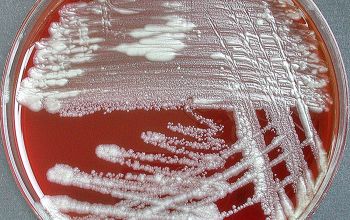

Mycobacterium chelonae (Mycobacteroides chelonae)
-
General information
M. chelonae belongs to the family of nontuberculous mycobacteria (NTM) classified in the rapidly growing mycobacteria (RGM)
Taxonomy
Family: Mycobacteriaceae
Genus: Mycobacteroides chelonae
Formely: Mycobacterium chelonae
M. chelonae is further grouped in the M. chelonae-abscessus group
M. chelonae
M. abscessus
M. immunogenum
Natural habitats / RGM
They are generally considered to be environmental saprophytes which are widely distributed in nature; they have been isolated from soil, dust, natural surface and municipal water, wild and domestic animals, and fish.
They resist the activity of disinfectants and biocides such as organomercurials, chlorine, and alkaline glutaraldehyde
Clinical significance
The most frequently recognized clinical diseases.
M. chelonae in normal hosts, localized post-traumatic wound infections and post-traumatic or post-surgical corneal infections and catheter infections
M. chelonae in immunosuppressed persons.
Disseminated skin infections in patients receiving corticosteroids and in organ transplant recipients and catheter infections.
M. abscessus in normal hosts, chronic lung infections, localized post-traumatic wound infections and surgical wound infections and chronic otitis media.
M. abscessus in immunosuppressed persons.
Disseminated skin infections in patients receiving corticosteroids and in organ transplant recipients
Localized infection in sporadic community-acquired disease usually occurs after a traumatic injury followed by potential soil or water contamination.
Such injuries as stepping on a nail, motor vehicle accidents, compound fractures, etc., are typical of the clinical histories seen in patients with RGM disease.
Pulmonary disease with M .chelonae is uncommon, and other atypical mycobacteria such as M. avium complex, M. kansasii, and M. abscessus are the more likely lung pathogens.
Confirmation of the presence or absence of mycobacteria in clinical specimens has traditionally required culture, because of the relative insensitivity of direct microscopy.
In general, clinical specimens that are normally sterile, such as blood, cerebrospinal fluid, or serous fluids, can be inoculated directly onto media.
In comparison, nonsterile specimens, such as sputum or pus, must be chemically decontaminated first in order to eliminate common bacteria and fungi that would overwhelm the culture.
However, decontamination procedures may inhibit the growth of mycobacteria, especially NTM, as well.
-
Gram stain
Straight or slightly curved Gram positive rods,
between 0.2-0.6 µm x 1.0-10 µm.
They do not stain well with Gram stain.
Gram stains of colonies showing faintly staining, "ghost-like" beaded Gram-positive bacilli are often helpful in establishing a diagnosis of mycobacteriosis.
Kinyoun:
Positive (acid-fast)
One acid-fast bacillus/slide is regarded as "suspicious" of a Mycobacterium infection.
-
Culture characteristics
-
Obligates aerobic / RGM
BA: colonies are non-pigmented, rough and wrinkled
primary isolation within 7 days on multiple types of solid media and the absence or slow appearance of any pigmentation
Separation of M. chelonae and M. abscessus cannot reliably be accomplished with HPLC or commercial DNA probes, but can be accomplished biochemically
1. utilization of citrate
2. drug susceptibility patterns
3. polymerase chain reaction-restriction length polymorphism analysis (PRA).
The clinical source of the mycobacterial isolate can be an important clue to the identification of the organism.
For instance M. abscessus is a common respiratory pathogen while M. chelonae is an exceedingly rare respiratory pathogen.
-
-
Characteristics
-
References
James Versalovic et al.(2011) Manual of Clinical Microbiology 10th Edition
Karen C. Carrol et al (2019) Manual of Clinical Microbiology, 12th Edition
Clinical and Taxonomic Status of Pathogenic Nonpigmented or Late Pigmenting Rapidly Growing Mycobacteria Barbara A. Brown-Elliott Clinical Microbiology Reviews, 2002, vol 5
Microbiology of nontuberculous mycobacteria Author: David E. Griffith UpToDate